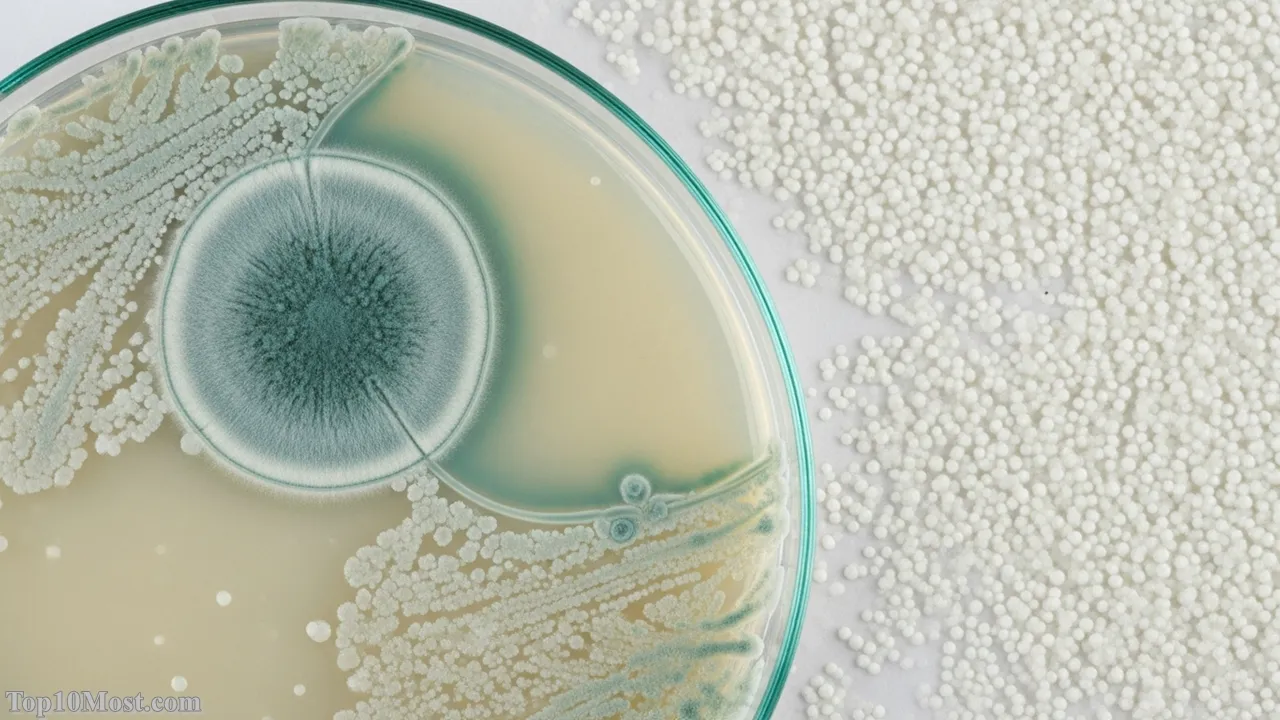
Top 10 Most Important Scientific Discoveries in History

Science is the perpetual engine of human progress, a process of reasoned analytical perspective that transforms our understanding of the universe. At Top 10 Most, we recognize that ranking such monumental achievements is subjective, as their criteria span from intellectual revolution to direct, life-altering societal impact. This list, carefully compiled and verified as of November 2025, represents the discoveries that laid the foundational blueprints for the modern world.
From the deep structures of biology to the vastness of the cosmos, these ten discoveries represent moments when humanity’s knowledge base experienced a fundamental shift. They are not merely inventions, but profound insights into the verifiable mechanics of nature, supported by generations of credible data. These breakthroughs are the bedrock upon which all contemporary science and technology rests, making them the most consequential events in the history of human inquiry.
Our commitment is to explain the MEANING behind this greatness, weighing factors like scope of influence, time since discovery, and ongoing relevance. In late 2025, we continue to witness the cascading effects of these foundational moments, from the development of CRISPR gene-editing technology to the deployment of interstellar probes, all powered by the knowledge contained within this definitive list.
Table of the Top 10 Most Important Scientific Discoveries
| Rank | Discovery/Concept | Primary Discovered/Developed By | Approximate Timeframe | Field |
|---|---|---|---|---|
| 1 | Germ Theory of Disease | Louis Pasteur & Robert Koch | Mid-19th Century (1860s) | Medicine/Biology |
| 2 | The Structure of DNA | Watson, Crick, & Franklin | 1953 | Genetics/Molecular Biology |
| 3 | Theory of General Relativity | Albert Einstein | 1915 | Physics/Cosmology |
| 4 | Classical Mechanics & Gravity | Sir Isaac Newton | Late 17th Century (1687) | Physics/Astronomy |
| 5 | Discovery of Penicillin | Alexander Fleming | 1928 | Medicine/Pharmacology |
| 6 | Theory of Evolution by Natural Selection | Charles Darwin & Alfred Russel Wallace | 1859 | Biology |
| 7 | Discovery of Electricity (Fundamental Laws) | Faraday, Maxwell, Tesla, et al. | 19th Century | Physics/Engineering |
| 8 | Periodicity of Elements (Periodic Table) | Dmitri Mendeleev | 1869 | Chemistry |
| 9 | Quantum Mechanics | Planck, Bohr, Heisenberg, et al. | Early 20th Century (c. 1900–1930) | Physics |
| 10 | Earth is Not the Center (Heliocentrism) | Nicolaus Copernicus (later Galileo) | 16th/17th Century | Astronomy |
The Top 10 Most Important Scientific Discoveries
Top 10. Earth is Not the Center (Heliocentrism)
The transition from a geocentric to a heliocentric model—placing the Sun, not the Earth, at the center of the solar system—represents the single most powerful shift in human perspective. Championed by Nicolaus Copernicus and later vindicated by the telescopic observations of Galileo Galilei in the early 17th century, this discovery shattered long-held religious and philosophical dogmas. The sheer intellectual courage required to challenge millennia of established thought, based purely on mathematical and observational evidence, sets the scene for the Scientific Revolution that followed, prioritizing empirical data above all else.

Its reason for ranking lies in its monumental philosophical and methodological impact: it was the first major step in removing humanity from a privileged, central position in the cosmos. This dethroning of Earth proved that the universe operated by immutable, external laws and was the catalyst for the entire modern scientific method. Without the realization that models of reality must conform to data, regardless of human vanity, much of the progress on this list would never have occurred.
The ultimate reflection of this discovery is that it allowed scientists to properly apply physics to celestial mechanics, directly paving the way for Kepler’s laws of planetary motion and later, Newton’s law of universal gravitation. It taught humanity a timeless lesson: that the truth about the universe is often counter-intuitive to our daily experience. In November 2025, every satellite launch and deep-space mission owes its existence to this foundational astronomical truth.
Key Highlights:
- Falsified the Ptolemaic/Aristotelian geocentric model that dominated thought for over 1,400 years.
- Primary proponents were Nicolaus Copernicus (mathematical model) and Galileo Galilei (telescopic evidence).
- Marked the true beginning of the Scientific Revolution in the 16th and 17th centuries.
Top 9. Quantum Mechanics
Emerging primarily from the work of Max Planck and Albert Einstein around 1900 and codified by Niels Bohr, Werner Heisenberg, and others in the following decades, Quantum Mechanics revolutionized our understanding of the subatomic world. It established that energy is not continuous but exists in discrete packets called quanta, fundamentally altering the deterministic view of classical physics. This framework is essential for explaining phenomena at the atomic and molecular levels, from the behavior of electrons in an atom to the emission spectra of light.

Its placement at number nine reflects its paradoxical nature: while it is the most intellectually challenging and non-intuitive discovery on this list, it is also the most fundamental to modern technology. Its principles govern virtually every piece of modern electronics, including semiconductors, lasers, and magnetic resonance imaging (MRI). The uncertainty principle and wave-particle duality demonstrated that reality at its core is probabilistic, not deterministic, challenging classical notions of cause and effect.
The incredible legacy of quantum mechanics is its ongoing relevance, especially in November 2025, with the furious pace of development in quantum computing and quantum encryption. This field promises the next great leap in computational power, utilizing phenomena like superposition and entanglement to solve problems currently intractable for the world’s most powerful supercomputers. It remains the most actively explored frontier of fundamental physics.
Key Highlights:
- Proposed that energy is delivered in discrete units called quanta (Planck, 1900).
- Governs the behavior of matter and energy at the atomic and subatomic level.
- Essential for the development of semiconductors, lasers, and quantum computing.
- The Heisenberg Uncertainty Principle demonstrated the probabilistic nature of reality.
Top 8. Periodicity of Elements (Periodic Table)
The discovery of the Periodicity of Elements by Dmitri Mendeleev in 1869 provided the crucial organizational framework for all of chemistry, moving the field from a catalog of isolated facts to a coherent, predictive science. Mendeleev’s breakthrough was not just listing the then-known elements, but arranging them by atomic weight in a way that revealed recurring patterns in their chemical properties. Crucially, he had the intellectual confidence to leave gaps for elements yet to be discovered and accurately predict their properties, such as Gallium and Germanium.

This systematic arrangement is vital because it codified the fundamental rule that the elements themselves follow a natural law, demonstrating an underlying order in the physical world. The table’s power to predict unknown elements and chemical reactions is a testament to the scientific method’s predictive value. It established the core grammar for how different forms of matter interact, directly supporting all later work in material science, industrial chemistry, and nuclear physics.
Even in November 2025, with the discovery of superheavy synthetic elements, the Periodic Table remains the single most recognizable and essential document in any science classroom. Its structure, which is a direct consequence of the quantum shell model of the atom, serves as a universal language for scientists, guiding everything from synthesizing new compounds to understanding astrophysical processes in distant stars.
Key Highlights:
- Organized elements by increasing atomic weight and recurring chemical properties (periodicity).
- Mendeleev famously predicted the existence and properties of elements like Gallium and Germanium.
- Provided the essential organizational blueprint for all modern chemistry.
Top 7. Discovery of Electricity (Fundamental Laws)
While the phenomenon of electricity had been observed for millennia, its mastery came in the 19th century through the pioneering work of scientists like Michael Faraday, James Clerk Maxwell, and Nikola Tesla. The crucial discovery was the unification of electricity and magnetism into a single force: electromagnetism, formalized by Maxwell’s equations. This established that light itself is an electromagnetic wave and provided the theoretical foundation necessary to harness electrical energy on an industrial scale.

The unparalleled societal impact of this discovery justifies its high ranking. The ability to generate, transmit, and utilize electric power is the single most transformative force for human civilization after fire. It enabled the telegraph, the telephone, and the entire structure of the industrial and information ages, dramatically improving the quality of life, driving economic growth, and instantly connecting the world. Without a fundamental understanding of electromagnetic forces, modern society simply would not exist.
In November 2025, as the world transitions to renewable energy and electric vehicles, the core principles established by these 19th-century giants remain unchanged. The discovery’s legacy is the global, interconnected electric grid, the internet running on fiber optics guided by electromagnetic principles, and every device from supercomputers to a simple light bulb, reflecting the ultimate practical application of a fundamental physical law.
Key Highlights:
- Michael Faraday discovered electromagnetic induction (the principle behind motors and generators).
- James Clerk Maxwell unified electricity and magnetism, proving light is an electromagnetic wave.
- The foundation of all modern electronics, telecommunications, and power grids.
Top 6. Theory of Evolution by Natural Selection
Published by Charles Darwin in 1859 and independently conceived by Alfred Russel Wallace, the Theory of Evolution by Natural Selection fundamentally changed how humanity views its own origin and place in the natural world. This discovery posits that all species of life descend over time from common ancestors, and the mechanism for this change is natural selection, where traits that aid survival and reproduction become more common in the population. It introduced a coherent, evidence-based, and elegant explanation for the vast biodiversity on Earth.

The profound reason for its high ranking is its power as a unifying principle for all of biology, providing the logical, scientific link between all living things, past and present. It is the core framework for fields ranging from genetics to ecology and medicine, explaining everything from antibiotic resistance in bacteria to the emergence of new viral strains. It was one of the first major scientific theories to directly address humanity’s own origin, forever integrating us into the continuity of the natural process.
Evolution remains one of the most vigorously tested and universally accepted scientific theories, constantly validated by new findings in genomics and paleontology, especially in November 2025, with the sequencing of new species’ genomes. Its central insight—that change occurs through differential reproductive success—is a philosophical and scientific triumph, providing a master key to life itself.
Key Highlights:
- Proposes that all life shares a common ancestor and changes through natural selection.
- Published by Charles Darwin in On the Origin of Species (1859).
- The foundational and unifying principle for all modern biology and life sciences.
Top 5. Discovery of Penicillin
Sir Alexander Fleming’s accidental discovery of Penicillin in 1928, followed by the crucial work of Howard Florey and Ernst Chain to develop it into a mass-producible drug, marks the dawn of the Age of Antibiotics. Fleming observed that a mold, Penicillium notatum, was inhibiting the growth of Staphylococcus bacteria on a culture plate. This realization unlocked the first truly effective medicine against bacterial infections, transforming conditions that were once certain death sentences, such as pneumonia, sepsis, and scarlet fever, into treatable illnesses.
Penicillin’s importance is measured in the sheer number of lives it has saved, estimated to be in the hundreds of millions since its widespread use during World War II. It directly created modern medical practice by enabling complex surgery, organ transplants, and cancer treatments, all of which rely on the ability to control infection. This discovery demonstrated the power of basic research to yield profoundly practical and benevolent results, fundamentally reshaping the demographic and health profile of the entire human population.
The legacy of this discovery in November 2025 is complex, as the world now grapples with antibiotic resistance, a direct consequence of evolution acting on microbes. However, Penicillin’s initial breakthrough spurred the global search for other antibiotics and continues to drive the urgent research into new antimicrobial compounds, confirming its status as the founding pillar of modern pharmacology and public health.
Key Highlights:
- Discovered by Alexander Fleming in 1928, leading to the first effective antibiotic.
- Revolutionized medicine by making bacterial infections, like pneumonia, treatable.
- Responsible for saving an estimated 200 million lives globally since its mass production.
Top 4. Classical Mechanics & Gravity
Sir Isaac Newton’s publication of the Philosophiæ Naturalis Principia Mathematica in 1687, where he established the Laws of Motion and Universal Gravitation, provided the first true framework for mathematical physics. His discovery showed that the force that causes an apple to fall is the very same force that keeps the planets in orbit. This unified terrestrial and celestial mechanics, providing a deterministic, quantitative model of the universe that could be calculated and predicted with stunning accuracy.

This discovery is ranked so highly because it established the gold standard for all subsequent scientific theorizing—a theory must be expressible in precise mathematical laws and be rigorously testable. Newton’s laws created the field of engineering as we know it, allowing for the precise design of machines, bridges, and infrastructure, ultimately powering the Industrial Revolution. It was the master key that unlocked predictable cause-and-effect in the physical world.
Even though its limitations were later revealed by Einstein’s relativity, Newtonian Mechanics remains the practically dominant theory for most of the engineering world in November 2025. Every rocket trajectory, from a lunar module to an interstellar probe like Voyager 1, is meticulously plotted using the very same mathematical principles laid out over three centuries ago, underscoring its timeless, practical authority.
Key Highlights:
- Established the Laws of Motion and the Law of Universal Gravitation (1687).
- Unified celestial and terrestrial physics under a single, mathematical framework.
- The foundational text for modern engineering, orbital mechanics, and classical physics.
Top 3. Theory of General Relativity
Albert Einstein’s Theory of General Relativity, published in 1915, redefined our most basic concepts of space and time. It established that gravity is not an invisible force, but rather a manifestation of the curvature of spacetime caused by mass and energy. This radical shift superseded Newtonian gravity, correctly predicting phenomena like the bending of light around massive objects (gravitational lensing) and the precise, anomalous orbit of Mercury. Its intellectual depth fundamentally altered the course of 20th-century physics and cosmology.

General Relativity merits its Top 3 placement due to its unparalleled intellectual impact on our understanding of the cosmos. It provided the tools to understand the largest structures of the universe, from the expansion of the universe (and the Big Bang theory) to the physics of black holes and gravitational waves, the latter of which were directly detected a century later in 2015. It represents the pinnacle of theoretical physics, providing a complete, self-consistent description of spacetime, gravity, and cosmic dynamics.
The theory is not merely academic; in November 2025, it is a daily necessity for global civilization. The precise functioning of the Global Positioning System (GPS) relies on continuous relativistic corrections. Without accounting for the time dilation effects of both Special and General Relativity, GPS satellite clocks would drift, and location data would become hopelessly inaccurate in minutes, confirming its vital, pervasive practical relevance.
Key Highlights:
- Redefined gravity as the curvature of spacetime caused by mass and energy.
- Correctly predicted gravitational lensing, black holes, and the existence of gravitational waves.
- Essential for the functional accuracy of the Global Positioning System (GPS).
Top 2. The Structure of DNA
The 1953 revelation of the Double-Helix structure of Deoxyribonucleic Acid (DNA) by James Watson and Francis Crick, based crucially on the X-ray diffraction work of Rosalind Franklin and Maurice Wilkins, is arguably the most important biological discovery of all time. This structure showed that DNA is a self-replicating molecule, providing the material basis for heredity. The specific pairing of nucleotide bases (A-T, G-C) provided the simple, elegant mechanism for copying genetic information, solving the millennia-old mystery of how life passes traits from one generation to the next.

The impact of understanding the genetic code is why it secures the number two spot: it launched the field of Molecular Biology and underpins all modern biological and medical sciences. It has led directly to gene sequencing, genetic engineering (like the revolutionary CRISPR technology in late 2025), forensic science, and the development of targeted therapies for genetic diseases. This discovery provided the ultimate blueprint—the source code—for life on Earth.
In November 2025, DNA is utilized daily in personalized medicine, vaccine development, and agricultural science. The ability to read, understand, and edit the instruction manual of life has created a new age of biology, allowing humanity to confront disease at its most fundamental level and pointing toward a future where genetic afflictions are curable.
Shutterstock
Key Highlights:
- Structure revealed in 1953 by Watson and Crick, utilizing data from Rosalind Franklin.
- The structure proved that DNA is a self-replicating molecule, the basis of heredity.
- Foundation for all molecular biology, genetics, and the invention of CRISPR.
Top 1. Germ Theory of Disease
The Germ Theory of Disease, primarily established by Louis Pasteur and Robert Koch in the mid-19th century, is the single most important scientific discovery for humanity’s immediate survival and proliferation. It established the verifiable truth that many diseases are caused by specific, identifiable microorganisms (germs, bacteria, and viruses) rather than by miasma, foul air, or divine punishment. Koch’s Postulates provided the formal criteria to prove a specific microbe caused a specific disease, introducing scientific rigor to epidemiology.

This discovery earns the top rank because its immediate, global, and cumulative impact on human life expectancy and public health is unparalleled. It led directly to the development of sterilization techniques, antiseptic surgery, pasteurization, and modern sanitation systems, including clean drinking water. Prior to this, doctors routinely killed patients by failing to wash their hands; Germ Theory provided the verifiable evidence that transformed medicine from guesswork to science, leading to the greatest increase in human population and longevity in history.
In November 2025, from handling a flu outbreak to developing the latest vaccine, every action in public health is a direct application of Germ Theory. Its legacy is the foundation of epidemiology, virology, and immunology. This fundamental insight—that the invisible world of microbes dictates human health—is the one discovery that has demonstrably saved more lives and altered the course of human history more profoundly than any other, confirming its place as the Top 1 Most Important Scientific Discovery in History.
Key Highlights:
- Established that diseases are caused by specific microorganisms (germs).
- Pioneered by Louis Pasteur (pasteurization, vaccines) and Robert Koch (Koch’s Postulates).
- Directly led to antiseptic surgery, sanitation, and vaccines, dramatically increasing human life expectancy.
Conclusion
The journey through these ten monumental breakthroughs is a testament to the cumulative nature of science—each discovery built upon the foundation of its predecessors. From the cosmic repositioning of the Earth by Copernicus to the microscopic mastery of life’s code through the structure of DNA, these are the keystones that define the modern human experience. The Germ Theory of Disease, standing at number one, powerfully reminds us that the most impactful knowledge often resides in the humble details that safeguard our very existence.
As we stand in November 2025, the pursuit continues. New frontiers like quantum computing and advanced gene editing are merely the latest iterations of this timeless process. At Top 10 Most, our reasoned analytical perspective confirms that the greatest discoveries are those that not only explain the world but empower humanity to thrive within it. We don’t just list the best—we explain the meaning behind this profound greatness, urging you to continue exploring the verifiable data that propels our world forward.